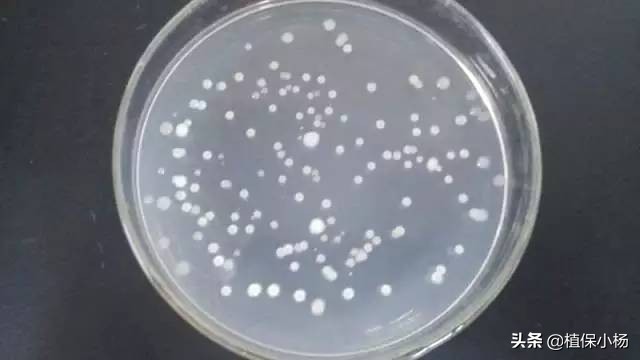
哈茨木霉菌枯草芽孢杆菌能混用么,哈茨木霉菌和枯草芽孢杆菌配比

一个菌剂里面有枯草芽孢杆菌和哈茨木霉菌,倒是相得益彰,咱们来看看这两种菌的作用:
1、枯草芽孢杆菌,是市面上应用最多的菌剂,也可以说是众多微生物菌生产厂家的一*法大**宝,最主要是因为原菌数量高,价格相对便宜,效果还不错,一般用枯草芽孢杆菌作为基础菌剂,复配其他功能性菌剂,一来保证了活菌数含量,二来保障了使用效果,控制成本不会过高。
枯草芽孢杆菌:细菌性菌剂,.解磷,防病、促根、抑制线虫、分解有机质
枯草芽孢杆菌能分解核酸和卵磷脂,促进对土壤难溶性磷的吸收,消耗游离氧,促进有益厌氧菌生长,间接抑制其它致病菌生长;分泌枯草菌素等活性物质,对致病菌有明显的抑制作用,分解过程中形成吲哚,促进根生长,分泌几丁质酶,分解线虫卵及病原真菌细胞壁,抑制线虫和病害,分解有机质提高土壤肥效。耐高温、耐盐碱,应用广泛。
2、哈茨木霉菌
真菌性菌剂:生防型菌剂,占位,寄生,防病,护根,促生

哈茨木霉菌这几年应用越来越多,各大科研院校先后对哈茨木霉菌设立专题研究,作为优秀的生物防病菌剂,未来应用将会越来越广。哈茨木霉菌通过快速在植物体表面抢占位点,形成保护罩,有效预防灰霉、*粉白**、炭疽、霜霉、叶霉等病害;并能分泌假性病原菌物质,诱惑并寄生于病原菌体,分泌酶溶解病原菌细胞壁,杀死病菌。

哈茨木霉菌菌丝适应多种土壤,缠绕在根系上,并在的根周围迅速生长,形成保护罩, 同时钝化病原菌的酶,阻止病原菌侵入植物细胞。增加抗病性,促进生长

哈茨木霉菌使用方法较为多样:基施、冲施、灌根、喷施都可以,但要值得注意的是,哈茨木霉菌对湿度有一定要求,保证湿度可以更好的促进菌群繁殖,过于干燥或干旱不利于菌群繁殖扩大。
一个菌剂里面有枯草芽孢杆菌和哈茨木霉菌,不管从促进生长,疏松土壤、提高肥料利用率还是抑制线虫、防病、抗病等方面都有不错的功效,是个不错的搭配!